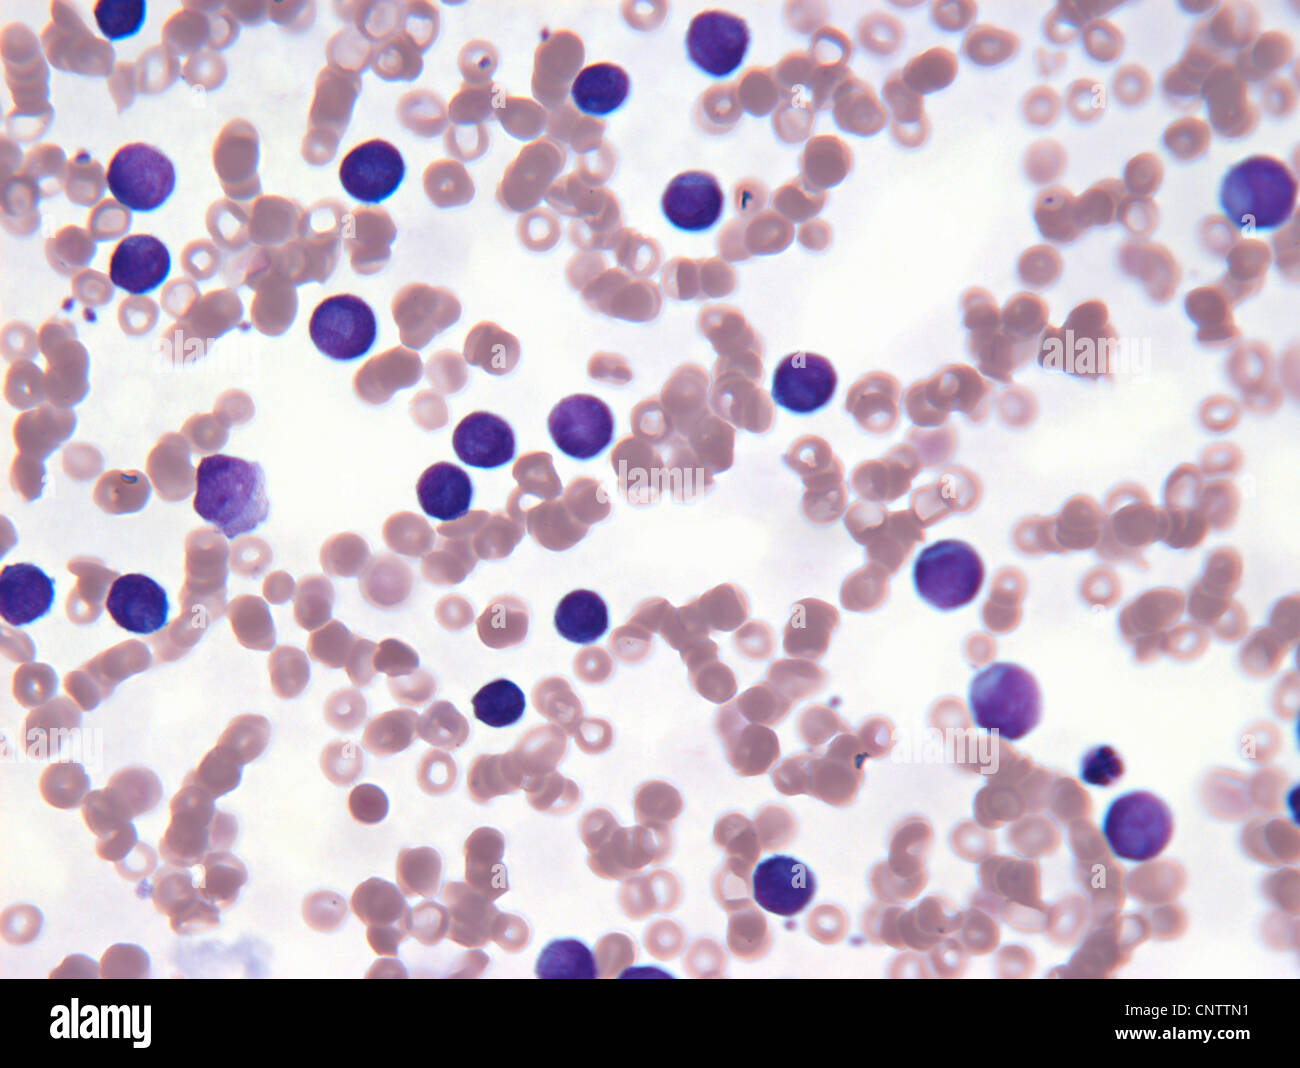
Neoplastiche di cellule linfocitarie nel sangue Foto Stock
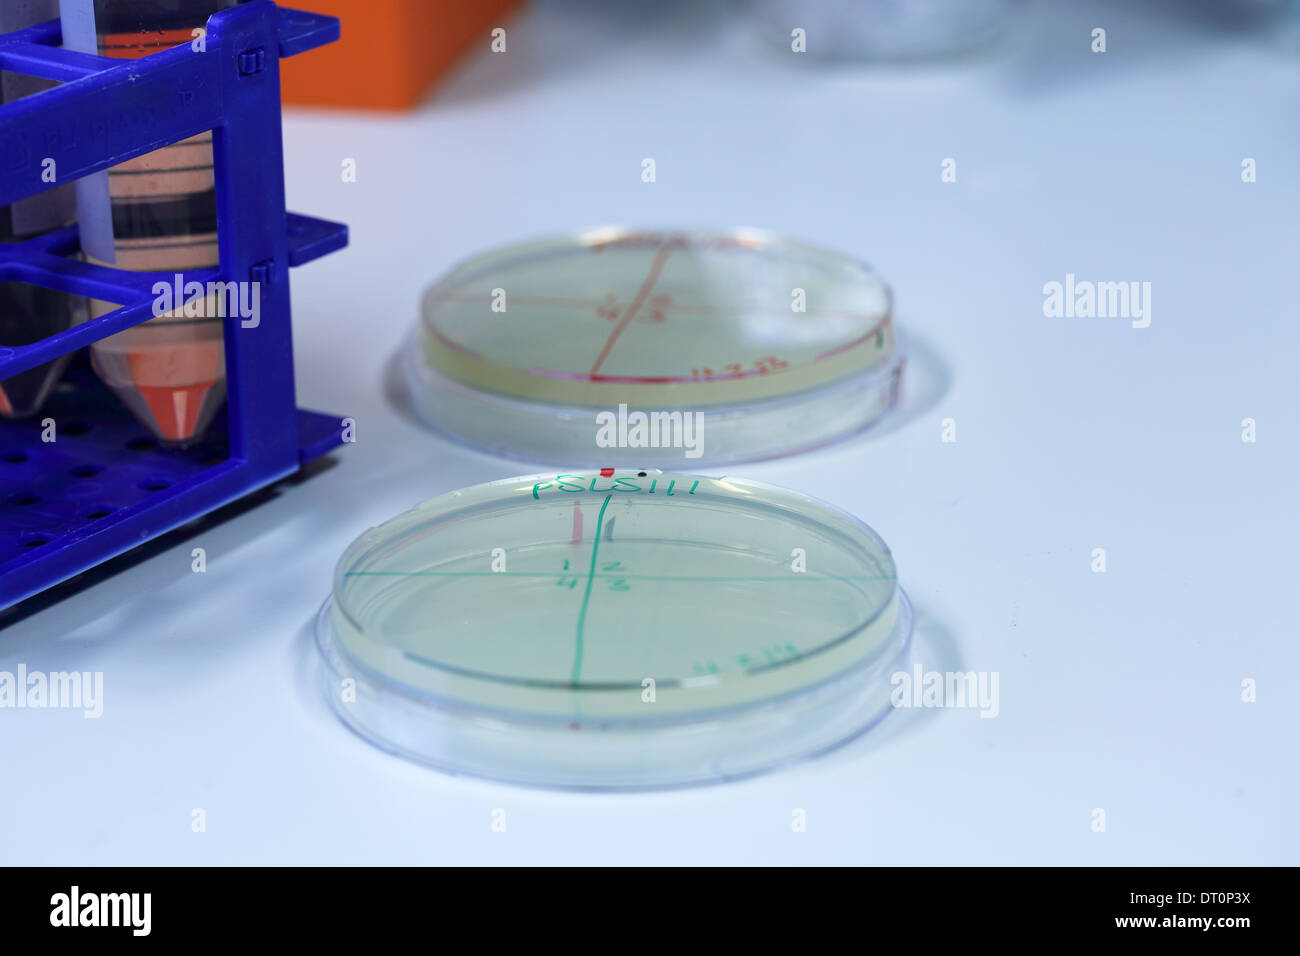
Piastra di petri con terreno in un laboratorio per i test Foto Stock

Cellula biologia Immagini Stock
(180,168)Filtri rapidi:
Cellula biologia Immagini Stock

RMC3PTM4–FAIRBANKS AK - 27 febbraio: "Cell R Ice' sculture di ghiaccio, 2010 Mondo ghiaccio Campionati d'arte Febbraio 27, 2010 a Fairbanks, Alaska

RF2JFWAWY–Globuli bianchi con nucleo e granulo. Membrana cellulare trasparente . Concetto di scienza e medicina background . 3D rendering .

RF2DHY2G6–Passi di autofagia. Diagramma schematico. Meccanismo naturale nella cella che rimuove i componenti non necessari. Illustrazione vettoriale

RF2GEG1FE–rendering 3d di cellule animali biologiche con sezione trasversale di organelli isolata su bianco

RF2BDAD3F–Vettore astratto con batteri e cellule di Bifidobatterio. Biologia scienza medica annuncio concetto banner design. Molecola medica di cellule di virus e batteri

RMR8TABX–Jennifer Doudna, American biochemist, professore di chimica e ingegneria chimica e il dipartimento di molecolare e biologia cellulare.

RF2BGJ757–Biologia di scienza medica. Sfondo vettoriale astratto con cellule e virus. Cellule mediche e biologia ricerca microscopica illustrazione

RF2H8ABWM–Lo scienziato utilizza il microscopio Leica per analisi biochimiche o di biologia cellulare, novembre 2021, San Francisco, USA.

RF2ATM2N5–I globuli rossi si riversano su sfondo nero. Illustrazione 3D, immagine concettuale. Tracciato di ritaglio incluso.

RF2J395MD–Max Planck Istituto di Biologia e genetica delle cellule molecolari della città. Famoso centro di ricerca in Sassonia dove lavorano gli scienziati. Edificio moderno

RF2TATJC7–Cellula senescente come cellule zombie come simbolo per la senescenza cellulare e l'invecchiamento nei tessuti viventi, poiché le molecole secrete dalla cellula possono riparare i tessuti

RFM3NH2H–Animale cellula umana struttura scienze educative. Microscopio 3d nucleo eucariotico organelle medicina analisi della tecnologia. Incandescente biologia colorato modello poster linea isolata illustrazione vettoriale

RF2FM2WYT–Anatomia cellulare animale. Diagramma vettoriale. La struttura di una cellula umana con parti marcate. Sezione trasversale di una cellula eucariotica. Illustrazione per la biologia,

RMD4XA2D–Sostanze chimiche. Varie sostanze chimiche memorizzati su un ripiano in un Cell Biology Laboratory

RF2WGHX7K–Biologia cellulare: I microscopi ottici vengono utilizzati per studiare la struttura e il comportamento delle cellule, compresi i loro organelli e processi cellulari.

RMR8TAAH–Jennifer Doudna, American biochemist, professore di chimica e ingegneria chimica e il dipartimento di molecolare e biologia cellulare.

RF2B7GPG7–Sfondo vettoriale astratto con cellule batteriche e virali. Biologia scienza medica annuncio concetto banner design. Illustrazione delle molecole mediche delle cellule virali

RF2H7XTB0–Microscopio Leica per analisi biochimiche e di biologia cellulare con campioni in background, novembre 2021, San Francisco, USA.

RF2BC3J5X–Dettagli di Coronavirus COVID-19 su cellule umane, illustrazione 3D come immagine microscopica all'interno del corpo umano basata su foto SEM SARS

RF2J395MK–Targhetta del Max Planck Institute of Molecular Cell Biology and Genetics in the City. Segno grigio con il logo CBG e le lettere. Struttura di ricerca

RF2B1P4AB–Concetto medico nel campo della nanotecnologia. Un nanobot studia o uccide una cellula di cancro. 3 d illustrazione.

RF2FK34B7–La biologia delle cellule staminali come concetto embrionale multicellulare o organismo adulto come simbolo per la terapia cellulare come illustrazione 3D.

RFM3NH24–Animale cellula umana struttura scienze educative. Microscopio 3d nucleo eucariotico organelle medicina analisi della tecnologia. Incandescente biologia colorato modello poster linea isolata illustrazione vettoriale

RF2DHY2T0–Cellula vegetale e struttura cellulare fungina (lievito). Sezione trasversale e anatomia della cellula. Tabella di biologia. Illustrazione vettoriale su sfondo bianco

RF2APJTM0–Analisi cellulare, duplicazione cellulare, studio di malattie infettive. Visione microscopica di microrganismi e batteri. Esame del sangue dei globuli rossi

RMD4XA36–Sostanze chimiche. Varie sostanze chimiche memorizzati su un ripiano in un Cell Biology Laboratory

RMR8TACC–Jennifer Doudna, American biochemist, professore di chimica e ingegneria chimica e il dipartimento di molecolare e biologia cellulare.

RF3D27MDY–Un'illustrazione 3D raffigura un neurone con i suoi dendriti e l'assone, circondato da numerosi anticorpi rossi a forma di Y

RF2BC3J9J–Dettagli di Coronavirus COVID-19 su cellule umane, illustrazione 3D come immagine microscopica all'interno del corpo umano basata su foto SEM SARS

RF2ANW62R–Batterio e microbi organismi. Microscopiche di salmonella, Bacillus o ameba organismi. Abstract vettore biologico sfondo

RFKTFBXY–Animale cellula umana struttura scienze educative. Microscopio 3d nucleo eucariotico organelle medicina analisi della tecnologia. Blu brillante poster di biologia modello linea isolata arte illustrazione vettoriale

RF2DHY2W8–Cellula vegetale e struttura cellulare animale. Sezione trasversale e anatomia cellulare. Tabella di biologia. Illustrazione vettoriale su sfondo bianco. Diagramma dettagliato

RMR8TAA3–Jennifer Doudna, American biochemist, professore di chimica e ingegneria chimica e il dipartimento di molecolare e biologia cellulare.

RF2WG3W14–il rendering 3d delle cellule è circondato da una membrana di plasma, che è una barriera sottile e flessibile che separa la cellula dal suo ambiente.

RFH56JKY–Università di Greifswald, Istituto di Anatomia e biologia cellulare, 1855 neoclassica della facciata in mattoni, Greifswald

RFKTFBY4–Animale cellula umana struttura scienze educative. Microscopio 3d nucleo eucariotico organelle medicina l'analisi. Luce bianca grigio poster di biologia modello linea isolata arte illustrazione vettoriale

RF3AHD5PR–Batteri Legionella pneumophila che causano malattie respiratorie come malattia dei legionari come una forma seria di polmonite come una microbiologia patologica

RF2BGJ3HX–Modello banner Web per microbiologia e vettoriali medici con batteri e virus 3d. Ricerca cellulare illustrazione microscopica scientifica
RF2JP842B–icona della linea di biologia cellulare, simbolo di contorno, illustrazione vettoriale, simbolo concettuale

RFD9NWN1–Immagine concettuale dell'apparato di Golgi. L'apparato di Golgi è un organulo trovata nella maggior parte delle cellule eucariotiche.

RMR8TAAG–Jennifer Doudna, American biochemist, professore di chimica e ingegneria chimica e il dipartimento di molecolare e biologia cellulare.

RF2WG3W16–il rendering 3d delle cellule è circondato da una membrana di plasma, che è una barriera sottile e flessibile che separa la cellula dal suo ambiente.

RFRMKTT8–Digital poligonale concetto di DNA. Struttura illustrazione dello stile. AI, IoT. Corsa modificabile. EPS 10

RF2JKWTMA–Canale ionico ligando-dipendente: L'attacco di una particolare molecola provoca l'apertura del canale.